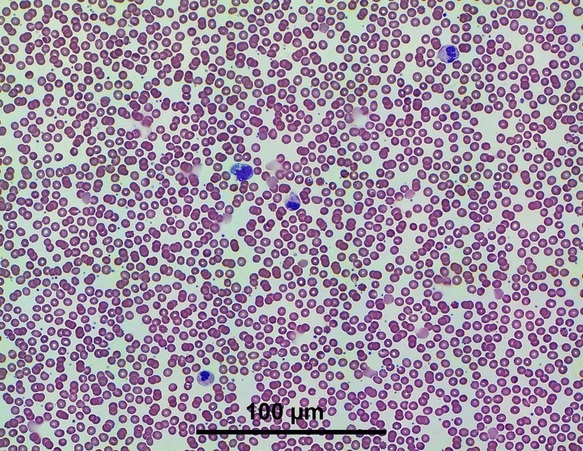
Picture

We can now achieve not only 4x, 10x, 20x, 40x, but also with the new 5-head turret and precision positioning we are achieving 100x (in oil and air, no kidding) of blood smear samples. Here is one sample (size reduced for web). Clicking on the image below will expand to very large size and take some time to load as it is ~4Mb jpg compressed. This tiled mosaic image was acquired in under 2 min and the original image is approximately 10000x8000 pixels.
Email me for more info on the new Mezoscope.

RSS Feed
RSS Feed